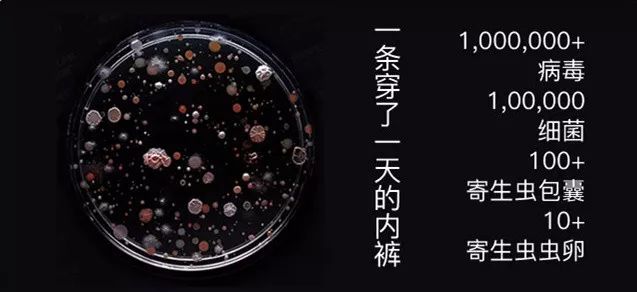
这*裤内**舒服抗菌，少买一件衣服也要换上（大牌同厂，男女都有，价格只要1/3！）

萧秋水按:
这款*裤内**,试用了两周,感觉的确是非常舒服,所以才放心大胆地推荐。这种舒服感怎么形容呢?是身上完全没有束缚感,特别是夏天到了,不舒服的*裤内**会让人感觉闷热,而这款完全没有。
我不太清楚女性有多少条*裤内**才够用,我自己得有几十条吧,由于*裤内**是亲肤穿着,所以在防菌消毒方面我也比较用心,之前推荐过《这瓶有200多年历史的内衣洗液,是女性的健康卫士》,我也一直在用。我较少出现妇科炎症,不清楚是不是和这种习惯有关,无论如何,多小心还是不错的。
以下为原推文:
大家好,我是一心。今年换季好像来的特别晚,不过春天总归是来了。
每年换季我的内衣*裤内**也会跟着换——*裤内**因为接触开放性*处私**,比起内衣更容易累积细菌,所以妇科医生都建议:内衣六月一换,*裤内**三月一换。
今天就给大家推荐一款抗菌*裤内**(原理我后面会讲),最重要的是来自耐克、阿迪、CK的代工厂,质量特别让人放心。男女都有,换季限时优惠,3条只要99元,没有品牌溢价,比普通*裤内**划算太多!

女士款穿上不勒痕、不夹痕、还有抑菌效果,80-200斤穿都合适。试过这条*裤内**,我的同事说:宁可少买一件衣服,*裤内**必须全换成它!
男士就没有女生这么麻烦,挑选标准就两条:舒服和透气。
舒服就是面料要舒服,最重要是不能太勒,尤其是有点啤酒肚的男生,特别怕穿上太紧绷。(男士*裤内**在后面会讲,如果着急,可以直接拉到后面)

要知道*裤内**遇到的所有问题,都在这里被解决了,尤其是抗菌问题(原理后面我会讲)!耐克、阿迪、CK等大牌同厂,质量特别让人放心。
推荐理由
1.超透气、不闷不紧,采访收集上百试穿体验,精确到5mm;
2.对妇科炎症的大肠杆菌、白念球等达到99%的抑菌作用;
3.大牌同厂,极度舒适,一条*裤内**连一根多余的线头都找不到!
1. 抗菌面料能有有效抑菌。
*裤内**可以挡去外来的侵扰,却躲不开内部的污染。一块小小布料穿上一天,就可能粘上各种排泄物和可能寄生的各种病菌。
所以即便是天天更换的*裤内**,经过几个月,仍然会有以万计数的病毒、寄生虫、虫卵,甚至还有粪便的残留。
而世界卫生组织公布的数据,80%的妇科炎症,都跟*裤内**不洁有关。
而且你有没有发现,*裤内**穿的时间久了裆部会越来越黄,越来越硬。根本原因就是*处私**分泌物渗透进布料纤维,无法100%清洗干净,越积越多。
应对方法其实很简单,一是定期换*裤内**,二是换一条抗菌*裤内**,减少感染概率(患过阴道炎、尿道炎的小伙伴,尤其需要),男性其实也一样!

一心今天给大家推荐的这款抗菌,裆部采用的是日本进口热感抗菌纯棉档里料:94%棉+6%氨纶。
热感抗菌的意思是,当你穿上后,如果体温在37.5℃以上,*裤内**上的“小红唇”就会消失,就是这样:

我查了资料,*裤内**用的抑菌材料是一种用于医学上健康安全的新型无机抑菌纳米材料,对皮肤没有任何刺激,也不会过敏性。
我还检查了这款*裤内**的抗菌报告:针对妇科炎症的大肠杆菌、白念球、等达到99%的抑菌作用,远超过普通*裤内**,价格却跟普通*裤内**一样便宜!

这个材料不仅有抑菌作用还有强大的减轻异味的作用!水洗50次也不会消失,穿这条*裤内**十分有益于健康。
2. 轻薄无痕,穿上很舒服。
抗菌是加分项,但*裤内**的本质还是要足够舒服、透气,好在,这款*裤内**用料、针织、剪裁都无可挑剔。

尤其春夏季,我的浅色衣服多,平常尤其是穿裙子和白色牛仔裤特别怕*裤内**透出颜色和印痕。
一般这时候,无痕*裤内**就是首选。今天推荐的这条*裤内**是0车缝。

△ 穿白色牛仔裤也不会露出*裤内**边缘痕迹
不会产生与皮肤的任何勒痕,从腰到臀,都能完美和肌肤贴合。穿上就感觉“没穿一样”,特别舒服!

透气排湿性也尤其好,80%锦纶+20%日本进口氨纶面料,一条*裤内**连一根多余的线头都找不到,清洗后干得很快。

这么舒服好穿,还是要跟普通*裤内**的面料对比:普通的锦氨面料中,氨纶也就占比8%左右,但这条*裤内**氨纶含量高达20%!
而且不仅含量大,用的还是日本进口20D氨纶,粗细程度堪比真丝!(你会发现居然有真丝的手感)
看过这么多*裤内**,我一上手就知道它不一般。

什么是20D氨纶?
日本进口的纱线20D,D数越小其密度越密。氨纶20D是氨纶中最细的一个!犹如人头发丝的一半粗细,弹力较好不易变形,回弹较好,非常的细腻稳定有弹性。
除了面料好之外,弹性也很好,穿上不会觉得勒或者感觉很紧。
会非常舒适地贴合臀部,没有*处私**摩擦带来的不适感,穿上很舒服。

跟棉质*裤内**比起来,不闷不热不粘,洗过之后还干的非常快。
南方*裤内**不干的困扰再也没有了!

出差的时候带上这条*裤内**,别管什么天气,在室内就可以快速风干,实在太方便。
▽ 被水湿透的部分,吹风机12s就能速干!

3. 好清洗,经期血迹都不怕,好评超多。
女生应该都知道,普通的棉质*裤内**,一旦不小心染上姨妈,真的很不好洗。
大力揉搓很容易把底档部分弄坏,不要说三个月了,一个月都穿不到。这和棉纱材质有很大关系,普通面料质量良莠不齐,吸附污垢的表面积也非常大。

我已经试过,这一款抗菌*裤内**洗起来很容易。
这是因为裆部面料用的是高级超细纤维,前面已经说了,每根只有头发的1/200!
它的表面紧致光滑的,不容易藏污纳垢,就算姨妈血漏出来,甚至抹上番茄酱,也能轻松洗干净。
▽ 番茄酱清洗测试

要知道这条*裤内**厚度也就0.5mm,就像婴儿皮肤那样又软又薄。
品牌方用了近一年的制版,采访收集了上百人的试穿反馈,反复调整近百次,才有这个精确到毫米的定版。
而且因为采用了全包臀的设计,完全不会有*裤内**夹臀的情况。

原价129元3条的禾氧小红唇*裤内**,现在,3条只要99元,相当于33元/条,没有品牌溢价,比我们平时买的品牌*裤内**还便宜2/3不止。而且还可以搭配购买,自己留两条给妈妈带一条试试。
新衣服可以少买,但贴身*裤内**值得更好的。

亲肤、安心一个都不能少
爱自己的女生都会穿的抗菌*裤内**
中腰、高腰可选
禾氧小红唇女士*裤内**换季限时优惠
原价129元
秋水粉丝专属价 99元/3条起

一共有两个版型:中腰和高腰,我先走一般都会穿高腰的*裤内**,更舒服自如,如果大家要搭配衣服,可以选中腰。
80-200斤穿都合适,尺码尽可以放心!

多个颜色可以选,纯天然植物印染,由浅到深的颜色都有。

我去看了一下这个品牌淘宝店铺的评价,也是一溜好评。
贴身的东西真的是容不得一点马虎。爱自己的女生一定要换上这条抗菌*裤内**。

△穿过的女生给了超多好评
4. 男人应该更讲究面料。
好了,再说说男士*裤内**。我做过一个小调查,还是有点出乎意料的,身边的朋友竟然都有给伴侣买新*裤内**的经历。
其实,这是很正确的,有的男生连衣服都会一连穿好几年不会换,这些事还是要我们操心。因为好的男士*裤内**其实会直接影响男性健康。

你一定见过男士*裤内**刚穿没多久就变得发黄、发硬,还松松垮垮的,穿久了会很不舒服。
我们常见的男士*裤内**都缺乏柔顺感,而且吸湿性不够,穿不了多久就变形!
今天推荐的这款*裤内**面料是奥地利兰精莫代尔,吸湿性比棉要高50%,而且水洗多少次都不会变硬、变黄。
真正奥地利进口的莫代尔,跟国产商场高端品牌爱慕先生同款面料!

除了面料舒服外,还一定不要勒。
传统*裤内**腰头一般采用的都是窄厚细腰带设计,而这款男士*裤内**采用了加宽的腰头,特别适合有啤酒肚的男士。

第二个重点就是透气。男士们最关心的裆部透气问题。
*裤内**的面料可以将水汽推至*裤内**表面微孔结构,透风透气,而且干的特别快。

还有一点很特别,这款*裤内**的U凸囊袋设计,裆部采用了特别双层面料,立体剪裁,仿佛一双手将隐私部位轻轻托起,不会有压迫感。
臀部设计也很特别,穿上不自觉有种臀部微翘的效果。

同样的面料类似的款式,知名品牌随便一条都好几百。

今天的推荐两条的价格还不到它的三分之一,要和身上最敏感的部位亲密接触,这一条足够好!
亲肤又透气的男士*裤内**
仿佛没穿的自由舒适
禾氧男士*裤内**换季限时优惠
原价149元
秋水粉丝专属价 79元/2条起
